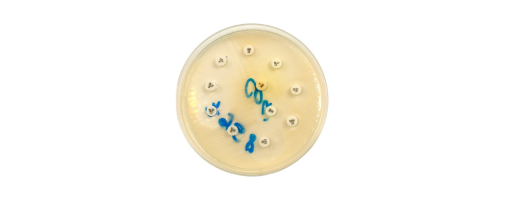

Atraso no início da dispensação do medicamento Trikafta no estado de São Paulo preocupa pacientes com fibrose cística e familiares
A promessa de acesso ao medicamento elexacaftor/tezacaftor/ivacaftor (Trikafta®) para pacientes com fibrose cística no Sistema Único de Saúde (SUS) ainda não se concretizou no estado de São Paulo, gerando frustração e preocupação entre profissionais da saúde, pacientes e suas famílias. Apesar da dispensação já ter sido iniciada em vários lugares do país em maio de […]
Entrevista com a especialista: conhecendo sobre testes de suscetibilidade antimicrobiana e sua importância na fibrose cística
Os testes de suscetibilidade antimicrobiana podem fazer parte da rotina de quem tem fibrose cística, mas você sabe o que eles são e a sua importância para quem tem a doença? Para responder essas e outras perguntas o Unidos pela Vida – Instituto Brasileiro de Atenção à Fibrose Cística entrevistou a biomédica Jannaina F. de […]
Confira os requisitos para doar sangue no Brasil

A doação de sangue é um ato de amor e solidariedade que pode salvar vidas, porém, alguns requisitos para doar sangue devem ser considerados na hora da decisão sobre se tornar doador. Por isso, o Unidos pela Vida – Instituto Brasileiro de Atenção à Fibrose Cística, compartilha agora informações importantes sobre o tema e que […]
Trikafta no SUS: saiba como pessoas elegíveis e com prescrição de uso podem acessar o modulador da proteína CFTR

Em maio de 2024, o elexacaftor/tezacaftor/ivacaftor (Trikafta®) começou a ser dispensado no Sistema Único de Saúde (SUS) para as pessoas elegíveis e com prescrição médica para o uso. Mas, como ter acesso ao medicamento? Confira abaixo as respostas para esta e outras perguntas, e compartilhe com seus amigos! Quem é elegível ao modulador? De acordo […]
Saiba o que será preciso fazer para acessar o Trikafta® e demais tecnologias do PCDT de fibrose cística quando disponíveis
O elexacaftor/tezacaftor/ivacaftor (Trikafta®) começará a ser dispensado no Sistema Único de Saúde (SUS) para as pessoas elegíveis e com prescrição médica para o uso. A incorporação desse medicamento no Sistema Único de Saúde (SUS) é uma das principais atualizações do novo Protocolo Clínico e Diretrizes Terapêuticas de Fibrose Cística (PCDT), que foi publicado em 2 […]
Portaria com a aprovação da atualização do PCDT de fibrose cística é publicada no Diário Oficial da União

Em 02 de maio, foi publicada no Diário Oficial da União (DOU) a Portaria Conjunta SAES/SECTICS nº 05 de 30 de abril de 2024, com a aprovação da atualização do Protocolo Clínico e Diretrizes Terapêuticas (PCDT) de fibrose cística. Clique aqui e confira a portaria na íntegra. O documento final você confere aqui. A atualização […]
Dia Mundial da Asma 2024: Participe!
Em 7 de maio, é celebrado o Dia Mundial da Asma de 2024. A maioria das 455.000 mortes no mundo relacionadas à asma ocorre em países de baixa e média renda, onde a asma é subdiagnosticada e subtratada, como o Brasil. Muitas vezes, pessoas com fibrose cística acabam recebendo o diagnóstico de asma grave por […]
Venda de álcool líquido 70% em farmácias e mercados volta a ser proibida no Brasil

A partir de 1º de maio de 2024, a venda de álcool líquido 70% voltará a ser proibida no Brasil pela Agência Nacional de Vigilância Sanitária (Anvisa) em estabelecimentos comerciais, como farmácias e supermercados. Apesar disso, a comercialização do álcool em gel 70%, indicada para higienização das mãos, segue autorizada nestes locais. Em 2020, por […]
O que são os moduladores e como eles funcionam?

Em 2023, a pesquisa do canadense John Richard Riordan que trouxe a descoberta da DeltaF508 – primeira mutação descrita como causadora da fibrose cística – completou 34 anos. Este estudo pivotal foi realizado em colaboração com os biólogos Francis Collins e Lap-Chee Tsui e publicado na revista Science em 08 de setembro de 1989, data […]
23º Encontro de Famílias Empresárias da Consultoria höft irá beneficiar o Unidos pela Vida

O 23º Encontro Beneficente de Famílias Empresárias acontecerá no dia 23 de maio, das 14h às 19h, e é uma realização da Consultoria höft Transição de Gerações. Este ano, mais uma vez, o Unidos pela Vida – Instituto Brasileiro de Atenção à Fibrose Cística será a entidade beneficiada com as inscrições feitas pelos participantes do […]



